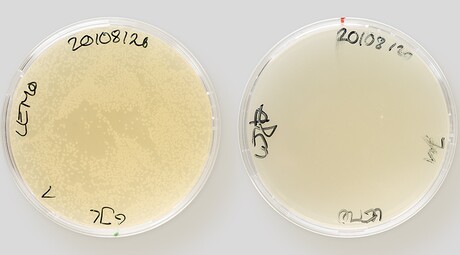

Novel antibiotic tricks bacteria through mimicry
Darobactin, a newly discovered antibiotic compound, kills many antibiotic-resistant pathogens by exploiting a tiny weak spot on their surface. An international team of researchers, led by the University of Basel, has now revealed the amazing mechanism at play here and thereby opened the door to developing new medicines.
An increasing number of bacterial pathogens are resistant to antibiotics, with the most dangerous sharing a common feature: a double membrane that is difficult to penetrate. Even when antibiotic agents are able to break into this shell, the bacteria just pump them right out again. Darobactin manages to circumvent these protective measures and kill nearly all problem pathogens; researchers have now been able to elucidate the mechanism of action.
In a study published in the journal Nature, the researchers describe how a deceptive manoeuvre enables darobactin to work: its shape mimics a special three-dimensional structure normally found only in proteins produced by bacteria as building blocks for their outer membrane. The structure is the ‘key’ for inserting the proteins into the outer shell at specific locations. Darobactin is a copy of this key. However, it does not act to penetrate the bacteria, but merely blocks the keyhole from the outside — like locking a door and then breaking off the key. As a result, the transport route for the bacteria’s shell components is obstructed and they die.
Similar mechanisms are already known in microbiology and are used by other drugs. The targeted binding structures, or keyholes, are usually quite large — at least in microbiological terms. In contrast, the target inhibited by darobactin is very small and cannot be detected by conventional methods. At the same time, Darobactin is larger than most drugs and cannot get through the entry ports of the bacteria.
“At the beginning, we were puzzled by this,” said Basel’s Sebastian Hiller and Timm Maier, the two principal authors of the study. Their teams immediately realised that darobactin does not act inside the pathogens but rather on the surface. There it interferes with the function of a protein known as BamA, which plays a central role in the construction of the double-protective membrane.
“But how exactly darobactin interacts with BamA was completely unclear,” Hiller said. It was only by combining several methods that the researchers finally identified the mechanism of action.
They discovered that darobactin attacks a true Achilles heel of the pathogens: it binds directly to the most important site of BamA, the so-called backbone atoms. Because these atoms hold the protein together and determine its shape, it is nearly impossible to change them — though changing them would be the usual way for the bacteria to fend off a new antibiotic. In fact, darobactin retained its effectiveness against all pathogens, for which Hiller and his team conducted laboratory tests that simulate resistance. In other words, the pathogens failed to change the broken lock.
These findings are a decisive step towards medical application, according to Basel infection biologist Dirk Bumann, who said, “Identifying darobactin’s mechanism of action is a major achievement, because it will enable further targeted improvement of darobactin and its development into an effective drug.” That gives a boost to the long-cherished hope of finding a new generation of antibiotics to fight many of today’s problem pathogens.
Please follow us and share on Twitter and Facebook. You can also subscribe for FREE to our weekly newsletters and bimonthly magazine.
Australia's first cases of H5 avian influenza confirmed
Positive results for H5 avian influenza (bird flu) have been confirmed in two seabirds found in...
AusBiotech partners with Tenmile
Designed to support Australia's homegrown life sciences innovation, AusBiotech has announced...
Australian CDC issues update in wake of Ebola outbreak
After the WHO determined the outbreak of Ebola in the DRC and Uganda to be a public health...



